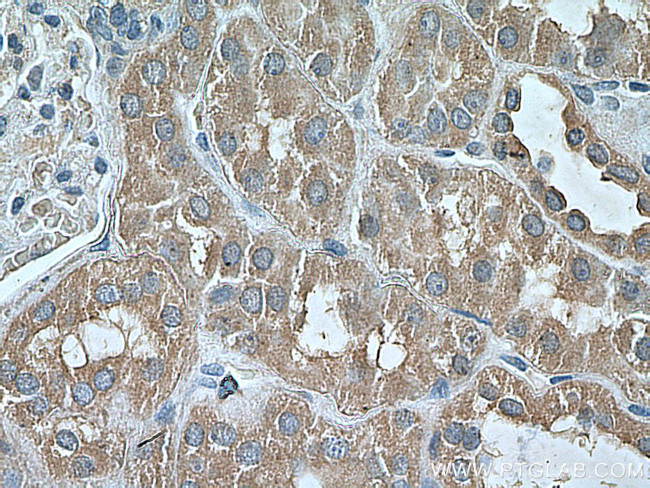
PEX5 Antibody in Immunohistochemistry (Paraffin) (IHC (P))

Search
Proteintech
PEX5 Monoclonal Antibody (1C2C3)
{{$productOrderCtrl.translations['antibody.pdp.commerceCard.promotion.promotions']}}
{{$productOrderCtrl.translations['antibody.pdp.commerceCard.promotion.viewpromo']}}
{{$productOrderCtrl.translations['antibody.pdp.commerceCard.promotion.promocode']}}: {{promo.promoCode}} {{promo.promoTitle}} {{promo.promoDescription}}. {{$productOrderCtrl.translations['antibody.pdp.commerceCard.promotion.learnmore']}}
产品信息
66309-1-IG
种属反应
宿主/亚型
分类
类型
克隆号
抗原
偶联物
形式
浓度
纯化类型
保存液
内含物
保存条件
运输条件
产品详细信息
Immunogen sequence: EGDLPNAVL LFEAAVQQDP KHMEAWQYLG TTQAENEQEL LAISALRRCL ELKPDNQTAL MALAVSFTNE SLQRQACETL RDWLRYTPAY AHLVTPAEEG AGGAGLGPSK RILGSLLSDS LFLEVKELFL AAVRLDPTSI DPDVQCGLGV LFNLSGEYDK AVDCFTAALS VRPNDYLLWN KLGATLANGN QSEEAVAAYR RALELQPGYI RSRYNLGISC INLGAHREAV EHFLEALNMQ RKSRGPRGEG GAMSENIWST LRLALSMLGQ SDAYGAADAR DLSTLLTMFG LPQ (340-639 aa encoded by BC010621)
靶标信息
The product of this gene binds to the C-terminal PTS1-type tripeptide peroxisomal targeting signal (SKL-type) and plays an essential role in peroxisomal protein import. Peroxins (PEXs) are proteins that are essential for the assembly of functional peroxisomes. The peroxisome biogenesis disorders (PBDs) are a group of genetically heterogeneous autosomal recessive, lethal diseases characterized by multiple defects in peroxisome function. The peroxisomal biogenesis disorders are a heterogeneous group with at least 14 complementation groups and with more than 1 phenotype being observed in cases falling into particular complementation groups. Although the clinical features of PBD patients vary, cells from all PBD patients exhibit a defect in the import of one or more classes of peroxisomal matrix proteins into the organelle. Defects in this gene are a cause of neonatal adrenoleukodystrophy (NALD), a cause of Zellweger syndrome (ZWS) as well as may be a cause of infantile Refsum disease (IRD). Alternatively spliced transcript variants encoding different isoforms have been identified.
仅用于科研。不用于诊断过程。未经明确授权不得转售。
生物信息学
蛋白别名: Peroxin-5; Peroxisomal C-terminal targeting signal import receptor; peroxisomal targeting signal 1 (SKL type) receptor; Peroxisomal targeting signal 1 receptor; peroxisomal targeting signal import receptor; peroxisomal targeting signal receptor 1; peroxisome biogenesis factor 5; Peroxisome receptor 1; PTS1 BP; PTS1 receptor; PTS1-BP
基因别名: PBD2A; PBD2B; PEX5; Pex5_predicted; PTS1-BP; PTS1R; PXR1; RCDP5
UniProt ID: (Human) P50542, (Rat) Q2M2R8
Entrez Gene ID: (Human) 5830, (Pig) 100512963, (Rat) 312703